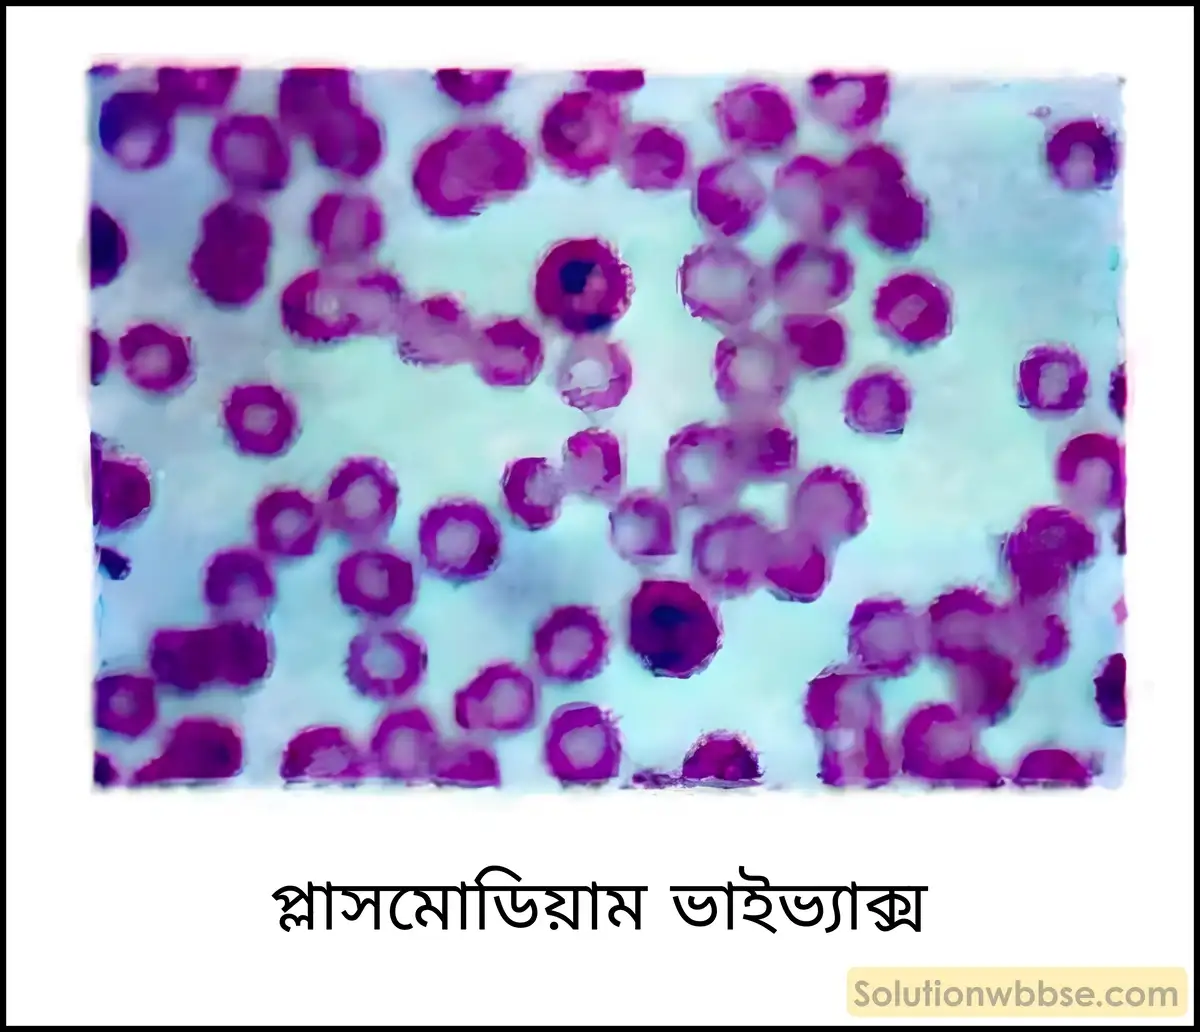
নবম শ্রেণী জীবনবিজ্ঞান - জীববিদ্যা ও মানবকল্যাণ - রচনাধর্মী প্রশ্ন ও উত্তর 7 প্লাসমোডিয়াম ভাইভ্যাক্স

এই আর্টিকলে আমরা নবম শ্রেণীর জীবন বিজ্ঞানের চতুর্থ অধ্যায় ‘জীববিদ্যা ও মানবকল্যাণ’ -এর গুরুত্বপূর্ণ রচনাধর্মী প্রশ্ন ও উত্তর নিয়ে আলোচনা করব। পশ্চিমবঙ্গ মধ্যশিক্ষা পর্ষদ (WBBSE) -এর সিলেবাস অনুযায়ী আসন্ন ইউনিট টেস্ট বা স্কুল পরীক্ষার প্রস্তুতির জন্য এই প্রশ্নগুলো অত্যন্ত জরুরি।

অনাক্রম্যতা কাকে বলে? ছকের মাধ্যমে অনাক্রম্যতার প্রকারভেদগুলি উল্লেখ করো।
অনাক্রম্যতা (Immunity) – জীবদেহে প্রবিষ্ট রোগসৃষ্টিকারী জীবাণু (ভাইরাস, ব্যাকটেরিয়া), প্রতিবিষ বা টক্সিন এবং বিভিন্ন প্রকারের বিজাতীয় প্রোটিনের বিরুদ্ধে দেহে প্রতিরোধ বা প্রতিরক্ষা ব্যবস্থা গড়ে তোলার স্বাভাবিক ধর্মকে, অনাক্রম্যতা বলে।
অনাক্রম্যতার প্রকারভেদ –

সহজাত অনাক্রম্যতা বলতে কী বোঝো? এর প্রকারভেদগুলি উদাহরণসহ আলোচনা করো।
সহজাত অনাক্রম্যতা (Innate or Inherited Immunity) – সাধারণ ও স্থায়ী যে রোগপ্রতিরোধ ক্ষমতা বা অনাক্রম্যতা, জন্মলগ্ন থেকে দেহে রোগ বা জীবাণুর বিরুদ্ধে সামগ্রিকভাবে কার্যকরী ভূমিকা গ্রহণ করে এবং বংশপরম্পরায় সঞ্চারিত হয়, তাকে সহজাত বা বংশগত বা জন্মগত অনাক্রম্যতা বলে।
সহজাত অনাক্রম্যতার প্রকারভেদ –
- বস্তুনিরপেক্ষ সহজাত অনাক্রম্যতা – যে অনাক্রম্যতা সাধারণত সমস্ত রকম জীবাণু সংক্রমণের বিরুদ্ধে দেহে প্রতিরোধ ব্যবস্থা গড়ে তোলে, তাকে বস্তুনিরপেক্ষ সহজাত অনাক্রম্যতা বলে।
- উদাহরণ – দেহে প্রবিষ্ট যে-কোনো জীবাণু বা বিজাতীয় বস্তুকে নিউট্রোফিল, মনোসাইট শ্বেতরক্তকণিকা, ম্যাক্রোফাজ কোশ আগ্রাসন পদ্ধতিতে ধ্বংস করে এবং দেহ রোগমুক্ত হয়।
- বস্তুনির্দিষ্ট সহজাত অনাক্রম্যতা – যে অনাক্রম্যতা কেবলমাত্র কোনো নির্দিষ্ট জীবাণুকে প্রাকৃতিকভাবে প্রতিরোধ করে দেহকে রোগমুক্ত রাখে, তাকে বস্তুনির্দিষ্ট সহজাত অনাক্রম্যতা বলে।
- উদাহরণ – কুকুরের মারণরোগ ‘ডিসটেমপার’ -এর জীবাণুর বিরুদ্ধে মানুষ জন্মলগ্ন থেকেই প্রতিরোধ ব্যবস্থা গড়ে তোলে। একারণে এই রোগটি কখনোই মানুষের দেহে হয় না।
অর্জিত অনাক্রম্যতা বলতে কী বোঝো? অর্জিত অনাক্রম্যতার প্রকারভেদগুলি উদাহরণসহ সংক্ষেপে আলোচনা করো।
অর্জিত অনাক্রম্যতা (Acquired Immunity) – জন্মের পর নির্দিষ্ট জীবাণু, জীবাণুসৃষ্ট টক্সিন বা অ্যান্টিটক্সিন সমৃদ্ধ সিরাম দেহে প্রবেশের দ্বারা নির্দিষ্ট রোগের বিরুদ্ধে যে অনাক্রম্যতা গড়ে ওঠে, তাকে অর্জিত অনাক্রম্যতা বলে।
অর্জিত অনাক্রম্যতার প্রকারভেদ –
সক্রিয় অর্জিত অনাক্রম্যতা –
ভাইরাস বা ব্যাকটেরিয়া বা বিজাতীয় প্রোটিনের অনুপ্রবেশ দ্বারা মানুষের দেহে যে নির্দিষ্ট অনাক্রম্যতা গড়ে ওঠে, তাকে সক্রিয় অর্জিত অনাক্রম্যতা বলে। এটি দু-প্রকার। যথা-
- প্রাকৃতিক সক্রিয় অর্জিত অনাক্রম্যতা – কোনো রোগের প্রভাবে দেহে সেই রোগের বিরুদ্ধে যে প্রতিরোধ ব্যবস্থা গড়ে ওঠে, তাকে প্রাকৃতিক অর্জিত সক্রিয় অনাক্রম্যতা বলে।
- উদাহরণ – বসন্ত, হাম বা মিজেলস্ প্রভৃতি রোগে আক্রান্ত হওয়ার পর রোগীর দেহে ওই রোগের জীবাণুর (অ্যান্টিজেন) বিরুদ্ধে নির্দিষ্ট অ্যান্টিবডি তৈরি হয়। এই অ্যান্টিবডি ভবিষ্যতে ওই রোগটিকে প্রতিরোধ করে বা রোগের বিরুদ্ধে অনাক্রম্যতা দান করে।
- কৃত্রিম সক্রিয় অর্জিত অনাক্রম্যতা – টিকাকরণের মাধ্যমে নির্দিষ্ট রোগের বিরুদ্ধে দেহে অনাক্রম্যতা গড়ে তোলাকে কৃত্রিম অর্জিত সক্রিয় অনাক্রম্যতা বলে।
- উদাহরণ – কলেরা, ডিপথেরিয়া, হাম, জলাতঙ্ক প্রভৃতি রোগের বিরুদ্ধে গঠিত অনাক্রম্যতা।
নিষ্ক্রিয় অর্জিত অনাক্রম্যতা –
মানুষের দেহে, অন্য কোনো প্রাণীর দেহে উৎপাদিত অ্যান্টিবডি (নির্দিষ্ট অ্যান্টিজেনের বিরুদ্ধে) বা সংবেদনক্ষম লিম্ফোসাইট সংগ্রহ করে ইনজেকশনের মাধ্যমে প্রবেশ করিয়ে যে অনাক্রম্যতা গড়ে তোলা হয়, তাকে নিষ্ক্রিয় অর্জিত অনাক্রম্যতা বলে। এক্ষেত্রে অ্যান্টিবডি উৎপাদনে মানুষের নিজস্ব অংশগ্রহণ থাকে না। এটি দু-প্রকার। যথা –
- প্রাকৃতিক নিষ্ক্রিয় অর্জিত অনাক্রম্যতা – জন্মগতভাবে সন্তান মায়ের কাছ থেকে মাতৃদুগ্ধপানের মাধ্যমে যে অনাক্রম্যতা লাভ করে, তাকে প্রাকৃতিক অর্জিত নিষ্ক্রিয় অনাক্রম্যতা বলা হয়।
- উদাহরণ – গর্ভস্থ ভ্রূণের দেহে প্ল্যাসেন্টার মাধ্যমে মায়ের দেহে সৃষ্ট অ্যান্টিবডি প্রবেশ করে এবং অনাক্রম্যতা গড়ে তোলে।
- কৃত্রিম নিষ্ক্রিয় অর্জিত অনাক্রম্যতা – ঘোড়া বা অন্য কোনো প্রাণীর দেহে নির্দিষ্ট অ্যান্টিজেনের বিরুদ্ধে সৃষ্ট অ্যান্টিবডি সংগ্রহ করে প্রয়োজনবোধে ইনজেকশনের মাধ্যমে মানুষের দেহে প্রবেশ করিয়ে অনাক্রম্যতা গড়ে তোলাকে কৃত্রিম অর্জিত নিষ্ক্রিয় অনাক্রম্যতা বলে।
- উদাহরণ – সাপে কামড়ালে মানুষের দেহে এই ধরনের অ্যান্টিবডি ইনজেকশন (অ্যান্টিভেনাম) দেওয়া হয়।
অ্যান্টিজেন কাকে বলে? অ্যান্টিজেনের গঠনগত বৈশিষ্ট্যগুলি লেখো।
অ্যান্টিজেন (Antigen) – যে বিজাতীয় বস্তু প্রাণীর দেহে প্রবেশের ফলে প্রোটিনধর্মী অ্যান্টিবডির সৃষ্টি হয় এবং পারস্পরিক আন্তঃক্রিয়ার মাধ্যমে দেহকে রোগমুক্ত রাখে, তাকে অ্যান্টিজেন বলে।

অ্যান্টিজেনের গঠনগত বৈশিষ্ট্য –
- বেশিরভাগ অ্যান্টিজেন প্রোটিনধর্মী।
- অ্যান্টিজেনের আণবিক ওজন সাধারণত 10,000 ডালটন বা তার বেশি হয়ে থাকে।
- অ্যান্টিজেনের যে বিশেষ স্থানে অ্যান্টিবডি যুক্ত হয়, তাকে অ্যান্টিজেনিক নির্ধারক অঞ্চল বা এপিটোপ (Epitope) বা ভ্যালেন্স বলে।
- অ্যান্টিজেন মনোভ্যালেন্ট বা মাল্টিভ্যালেন্ট হতে পারে।
- সমগ্র অণুজীব (ব্যাকটেরিয়া, ভাইরাস প্রভৃতি) বা অণুজীবের দেহাংশ বা অণুজীব নিঃসৃত পদার্থ অ্যান্টিজেনরূপে কাজ করে।
- অ্যান্টিজেন অবশ্যই দেহে অ্যান্টিবডি তৈরি হওয়ার জন্য উদ্দীপনা সৃষ্টি করে এবং অ্যান্টিবডি-অ্যান্টিজেন বিক্রিয়ায় অংশগ্রহণ করে।
অ্যান্টিবডি কাকে বলে? অ্যান্টিবডির গঠনগত বৈশিষ্ট্যগুলি লেখো। অথবা, অ্যান্টিবডির গঠন চিত্রসহ আলোচনা করো।
অ্যান্টিবডি (Antibody) – দেহে অ্যান্টিজেন অনুপ্রবেশের পর অনাক্রম্যতাতন্ত্রকে উদ্দীপিত করে যে বিশেষ ধরনের প্রোটিনধর্মী পদার্থ উৎপাদিত হয়ে অ্যান্টিজেনকে নিষ্ক্রিয় করে, তাকে অ্যান্টিবডি বলে।
অ্যান্টিবডির গঠনগত বৈশিষ্ট্য –
- অ্যান্টিবডি ইমিউনোগ্লোবিউলিন (Ig) প্রোটিন শ্রেণির অন্তর্গত।
- অ্যান্টিবডি B-লিম্ফোসাইট দ্বারা উৎপাদিত হয় এবং গঠন ইংরেজি অক্ষর ‘Y’ আকৃতির হয়।
- একটি আদর্শ অ্যান্টিবডির গঠনে চারটি পলিপেপটাইড শৃঙ্খল – দুটি ভারী শৃঙ্খল বা H-চেন (Heavy Chain) এবং দুটি হালকা শৃঙ্খল বা L-চেন (Light Chain) থাকে।
- প্রতিটি ভারী শৃঙ্খলে 400টি এবং প্রতিটি হালকা শৃঙ্খলে 200টি অ্যামিনো অ্যাসিড উপস্থিত থাকে।
- প্রতিটি শৃঙ্খল পরস্পরের সঙ্গে ডাইসালফাইড বন্ধনী দ্বারা যুক্ত থাকে।
- আকৃতির অ্যান্টিবডির গঠনে দুটি অ্যান্টিজেন বন্ধন স্থান থাকে। একে Fab বা ফ্র্যাগমেন্ট অ্যান্টিজেন বাইন্ডিং স্থান বলে। এই স্থানটি Lock & Key পদ্ধতিতে অ্যান্টিজেনকে আবদ্ধ করে। বাইন্ডিং সাইটে অ্যান্টিজেন যুক্ত হলে একটি যৌগ গঠিত হয়, যাকে অ্যান্টিজেন-অ্যান্টিবডি কমপ্লেক্স বলে।
- Fab অঞ্চলের যে নির্দিষ্ট স্থানটি অ্যান্টিজেনের সঙ্গে যুক্ত হয়, তাকে অ্যান্টিজেন বাইন্ডিং সাইট বা প্যারাটোপ বলে।
- অ্যান্টিবডির যে অংশ অলিগোস্যাকারাইড দিয়ে গঠিত সেই অংশটি অ্যান্টিজেন আবদ্ধ করতে ব্যর্থ, সেই অংশটিকে ফ্র্যাগমেন্ট ক্রিস্টালাইজেবল প্রান্ত বা Fc বলে। এটি কেবলমাত্র H-চেন দ্বারা গঠিত।
- ভারী ও হালকা শৃঙ্খলের মধ্যে দুটি সুস্পষ্ট অংশ দেখা যায়। যথা –
- অগ্রভাগে পরিবর্তনশীল অঞ্চল (Variable Region or ‘V’) বা অ্যান্টিজেন বন্ধনকারী অঞ্চল এবং
- নীচের দিকে ধ্রুবক অঞ্চল (Constant Region or ‘C’)।
- বেশিরভাগ অ্যান্টিবডিতে দুটি পরিবর্তনশীল অঞ্চল থাকে, তাই একে বাইভ্যালেন্ট বলা হয়।

মানবদেহে অ্যান্টিবডির প্রকারভেদ, অবস্থান ও কাজ ছকের মাধ্যমে উল্লেখ করো।
| অ্যান্টিবডি (%) | অবস্থান | কাজ |
| ইমিউনোগ্লোবিউলিন G (IgG) [80%] | রক্তে বেশি থাকে, লসিকা, অস্ত্রেও পাওয়া যায়। | 1. প্ল্যাসেন্টা ভেদ করে মায়ের রক্ত থেকে ভ্রূণের রক্তে প্রবেশ করে বলে, একে ম্যাটারনাল অ্যান্টিবডি (Maternal antibody) বলে। 2. ব্যাকটেরিয়া ও ভাইরাস ধ্বংস করে। |
| ইমিউনোগ্লোবিউলিন A (IgA) [10-15%] | অশ্রু, ঘর্ম, লালারস, শ্লেষ্মা এবং স্তনগ্রন্থি থেকে ক্ষরিত কোলোস্ট্রামে পাওয়া যায়। | অনাবৃত দেহতলকে জীবাণুর আক্রমণ থেকে রক্ষা করে। |
| অনাবৃত দেহতলকে জীবাণুর আক্রমণ থেকে রক্ষা করে। | রক্ত ও লসিকায় উপস্থিত। সবচেয়ে বড়ো আকারের অ্যান্টিবডি। | 1. ভ্রূণের দেহে প্রথম সংশ্লেষিত অ্যান্টিবডি। 2. ব্যাকটেরিয়া ও অন্যান্য জীবাণু প্রতিরোধে সাহায্য করে। |
| ইমিউনোগ্লোবিউলিন D (IgD) [0.2%] | রক্তে উপস্থিত। B-লিম্ফোসাইটের পর্দা সংলগ্ন থাকে। | B-লিম্ফোসাইটকে উদ্দীপিত করে। |
| ইমিউনোগ্লোবিউলিন E (IgE) [0.002%] | রক্তে উপস্থিত। মাস্ট কোশ ও বেসোফিল শ্বেত রক্তকণিকার পর্দার ওপর সংলগ্ন থাকে। | IgE অ্যালার্জেনের উপস্থিতিতে সৃষ্ট অ্যালার্জির ওপর ক্ষতিকারক প্রভাব বিস্তার করে। |
ইমিউন রেসপন্স কাকে বলে? এর সংক্ষিপ্ত ধারণা দাও।
ইমিউন রেসপন্স (Immune Response) – কোনো বহিরাগত অ্যান্টিজেন বা বিজাতীয় বস্তু দেহে প্রবেশের ফলে, দেহের ইমিউনতন্ত্র সক্রিয় হয়ে ওঠে এবং ওই অ্যান্টিজেনের বিরুদ্ধে যে প্রতিক্রিয়ার সৃষ্টি করে, তাকে ইমিউন রেসপন্স বলে।
ইমিউন রেসপনসের কার্যপদ্ধতি –
- দেহের ইমিউনতন্ত্র ও প্রকার কোশের সমন্বয়ে গঠিত-ফ্যাগোসাইট, T-Cell এবং B-Cell। T-Cell এবং B-Cell হল আসলে T-লিম্ফোসাইট এবং B-লিম্ফোসাইট।
- দেহে বিজাতীয় বস্তু বা অ্যান্টিজেন ঢুকলে ম্যাক্রোফাজ ফ্যাগোসাইটোসিস বা আগ্রাসন পদ্ধতিতে জীবাণুকে আত্মসাৎ করে। এরপর T-কোশ বিশেষ ভূমিকা নেয় এবং ইমিউন রেসপনসের সৃষ্টি হয়। এই ইমিউন রেসপনস দুটি পর্যায়ে ঘটে –
- কোশভিত্তিক অনাক্রম্যতা (Cell-mediated Immunity) – এই প্রকার অনাক্রম্যতায় T-কোশ সক্রিয় হয়। থাইমাস গ্রন্থি থেকে T-লিম্ফোসাইট উৎপত্তি লাভ করে। দেহে রোগজীবাণু প্রবেশ করলে ম্যাক্রোফাজ তাকে গ্রাস করে। T লিম্ফোসাইট ম্যাক্রোফাজযুক্ত অ্যান্টিজেনকে ধ্বংস করে। দেহে অ্যান্টিজেন প্রবেশ করলে প্রথমে হেল্পার T-কোশ থাইমাসে T-কোশকে সক্রিয় করে এবং সক্রিয় T-লিম্ফোসাইটে পরিণত হয়। তারপর এই T-লিম্ফোসাইট সাইটোটক্সিক -কোশে পরিণত হয় এবং বহিরাগত প্যাথোজেনকে ধ্বংস করে।
- রসভিত্তিক অনাক্রম্যতা (Humoral Immunity) – এই অনাক্রম্যতা B-লিম্ফোসাইট দ্বারা ঘটে। T-কোশ যুক্ত অ্যান্টিজেন B-কোশের সংস্পর্শে আসলে B-কোশ সক্রিয় হয় এবং B-লিম্ফোসাইট গঠন করে। এই B-লিম্ফোসাইটগুলি প্লাজমা কোশ তৈরি করে অ্যান্টিবডি সংশ্লেষ করে। অ্যান্টিবডিগুলি ভাইরাল অ্যান্টিজেন কোশ ধ্বংস করে। অন্যদিকে B-কোশ মেমরি কোশ বা স্মৃতিকোশ (Memory cell) উৎপন্ন করে, যা পরবর্তীকালে ওই ধরনের অ্যান্টিজেনের সংক্রমণে বাধা দেয়।

অ্যান্টিজেন-অ্যান্টিবডি আন্তঃক্রিয়া কাকে বলে? কয় প্রকার ও কী কী?
যে প্রক্রিয়ায় কোনো অ্যান্টিজেন নির্দিষ্ট অ্যান্টিবডির সঙ্গে যুক্ত হয়ে জটিল অদ্রবণীয় গঠন তৈরি করে এবং পরিশেষে অ্যান্টিজেন ধ্বংস হয়, তাকে অ্যান্টিজেন-অ্যান্টিবডি আন্তঃক্রিয়া বলে।
অ্যান্টিজেন-অ্যান্টিবডি আন্তঃক্রিয়া 5 প্রকারের হয়। যথা –
- প্রশমিতকরণ বা নিউট্রালাইজেশন – অ্যান্টিজেনের টক্সিক অঞ্চল অ্যান্টিবডি দ্বারা আবৃত হয় এবং ভিরুলেন্ট অ্যান্টিজেন আভিরুলেন্ট অ্যান্টিজেনে পরিণত হয়।
- তঞ্চিতকরণ বা আগ্লুটিনেশন – অ্যান্টিবডি অ্যান্টিজেনগুলিকে তঞ্চিত করে।
- অপসোনাইজেশন – অপসোনিন (অ্যান্টিবডি) অ্যান্টিজেনের পরিধিতলের সঙ্গে যুক্ত হয় এবং এদের শনাক্তকরণে সাহায্য করে।
- লাইসিন – লাইসিন অ্যান্টিবডি অ্যান্টিজেনকে (ব্যাকটেরিয়া) বিদীর্ণ করে।
- অধঃক্ষেপণ বা প্রেসিপিটেশন – অ্যান্টিবডি দ্রবীভূত অ্যান্টিজেনের সঙ্গে যুক্ত হয়ে তাদের অদ্রবীভূত গঠনে পরিণত করে এবং অধঃক্ষেপণ ঘটায়।
টিকাকরণ কাকে বলে? কে, কীভাবে টিকাকরণ পদ্ধতি আবিষ্কার করেন?
টিকাকরণ (Vaccination) – যে পদ্ধতিতে টিকা বা প্রতিষেধক দেহে অনুপ্রবেশ করিয়ে নির্দিষ্ট রোগের বিরুদ্ধে দেহে রোগ প্রতিরোধ ব্যবস্থা গড়ে তোলা হয়, তাকে টিকাকরণ বা ভ্যাকসিনেশন বলে।
ড. এডওয়ার্ড জেনার (Dr. Edward Jenner, 1796) সর্বপ্রথম টিকা ও টিকাকরণ আবিষ্কার করেন।
টিকাকরণ আবিষ্কারের ইতিহাস –
- অষ্টাদশ শতাব্দীতে গুটি বসন্ত (Small pox) রোগটি মহামারির আকার ধারণ করেছিল। ড. জেনার লক্ষ করেছিলেন যে গোরু লালন-পালনকারী মহিলাদের গুটিবসন্ত হয় না।
- এই সমস্ত মহিলারা জীবনের কোনো না কোনো সময়ে গোবসন্ত দ্বারা আক্রান্ত হয়েছে, যা গোরুর দেহ থেকে তাদের দেহে সংক্রামিত হয়েছিল। তাই তারা গুটি বসন্তের অনাক্রম্যতা অর্জন করেছে।
- এই পর্যবেক্ষণের ওপর ভিত্তি করে, তিনি ফিলিপস (Philips) নামক একটি বালকের দেহে প্রথমে গোবসন্তের জীবাণু (ভাইরাস) প্রবেশ করান। ছেলেটি গোবসন্ত (Cow pox) দ্বারা আক্রান্ত হয় এবং তার দেহে গোবসন্তের লক্ষণ ফুটে ওঠে।
- এরপর ড. জেনার বালকটির দেহে গুটি বসন্তের (Small pox) জীবাণু (ভাইরাস) প্রবেশ করান।
- ড. জেনার লক্ষ করেন বালকটির দেহে কোনো গুটি বসন্তের লক্ষণ প্রকাশ পায়নি। অর্থাৎ, ছেলেটি গুটি বসন্ত দ্বারা আক্রান্ত হয়নি।
- এই পর্যবেক্ষণের পরেই তিনি টিকা এবং টিকাকরণ পদ্ধতি সম্পর্কে ধারণা দেন এবং পৃথিবীতে বিভিন্ন মারণ রোগের বিরুদ্ধে টিকাকরণ অভিযান শুরু হয়।
টিকা কাকে বলে? চারটি প্রচলিত টিকার নাম, প্রকৃতি এবং তাদের দ্বারা বাধাপ্রাপ্ত রোগের নাম ছকের মাধ্যমে লেখো।
টিকা (Vaccine) – যে রোগসৃষ্টিকারী সজীব, দুর্বল জীবাণু বা জীবাণুর উপাংশ পরিবর্তিত অবস্থায় দেহে মৌখিকভাবে বা ইনজেকশনের মাধ্যমে প্রবেশ করিয়ে নির্দিষ্ট রোগের বিরুদ্ধে রোগ প্রতিরোধ ব্যবস্থা গড়ে তোলা হয়, তাকে টিকা বা ভ্যাকসিন বলে।
| টিকার নাম | টিকার প্রকৃতি | বাধাপ্রাপ্ত রোগ |
| ওরাল পোলিয়ো ভ্যাকসিন (OPV) | সজীব এবং দুর্বল জীবাণু থেকে তৈরি করা হয়। | পোলিয়ো |
| বিসিজি (BCG) | দুর্বল ব্যাকটেরিয়া থেকে তৈরি করা হয়। | যক্ষ্মা বা টিউবারকিউ-লোসিস |
| টাইফয়েড ভ্যাকসিন (TAB) | মৃত ব্যাকটেরিয়া থেকে তৈরি করা হয়। | টাইফয়েড |
| ট্রিপল অ্যান্টিজেন DPT (ডিপথেরিয়া, পারটুসিস, টিটেনাস টক্সয়েড) | টক্সয়েড বা অধিবিষ থেকে তৈরি করা হয়। | ডিপথেরিয়া, পারটুসিস বা হুপিং কাশি এবং টিটেনাস |
| MMR | সজীব এবং দুর্বল জীবাণু থেকে তৈরি করা হয়। | হাম, মাম্পস, রুবেলা |
| HBV (হেপাটাইটিস B ভ্যাকসিন) | মৃত জীবাণু (ভাইরাস) থেকে তৈরি করা হয়। | হেপাটাইটিস |
টিকার প্রকারভেদগুলি উদাহরণসহ উল্লেখ করো।
টিকার প্রকারভেদ – উৎসের ওপর নির্ভর করে টিকাকে 6 ভাগে ভাগ করা হয়। যথা –
- মৃত জীবাণু বা প্যাথোজেন থেকে উৎপাদিত টিকা – টাইফয়েড রোগের জন্য TAB ভ্যাকসিন, পোলিয়োর জন্য সক (Salk) ভ্যাকসিন, জলাতঙ্কের জন্য র্যাবিস ভ্যাকসিন।
- সজীব, দুর্বল জীবাণু থেকে প্রস্তুত টিকা – হাম (মিজেলস), মাম্পস, BCG, পোলিয়োর স্যাবিন (OPV) ভ্যাকসিন।
- সজীব এবং সম্পূর্ণ ভিরুলেন্ট জীবাণু থেকে প্রস্তুত টিকা – গুটি বসন্তের জন্য টিকা।
- টক্সয়েড দ্বারা প্রস্তুত টিকা – ডিপথেরিয়া, টিটেনাস রোগের টিকা।
- অ্যাটিনিউয়েটেড ভাইরাস থেকে প্রস্তুত টিকা – হাম, মাম্পস এবং রুবেলা (MMR) টিকা।
- সারফেস ভাইরাস দ্বারা প্রস্তুত টিকা – ইনফ্লুয়েঞ্জা টিকা।
- কোশীয় অংশ থেকে প্রস্তুত টিকা – নিউমোকক্কাল ভ্যাকসিন (ক্যাপসুলের পলিস্যাকারাইড অংশ থেকে প্রস্তুত হয়) বা হেপাটাইটিস B-ভ্যাকসিন।
ডায়ারিয়া রোগের প্রকৃতি, উপসর্গ, সংক্রমণের পদ্ধতি ও প্রতিরোধ ব্যবস্থা সংক্ষেপে লেখো।
রোগের নাম – ডায়ারিয়া।
রোগের প্রকৃতি – এন্টামিবা হিস্টোলাইটিকা (Entamoeba histolytica) নামক পরজীবী বা আদ্যপ্রাণী ঘটিত রোগ।

রোগের উপসর্গ –
- রোগী বারে বারে পাতলা মলত্যাগ করে।
- শরীরে জলাভাব দেখা দেয়।
- মুখ ও গলা শুকিয়ে যায় এবং তলপেটে খিল ধরা ভাব থাকে।
- পেটে যন্ত্রণা হয়।
রোগসংক্রমণ পদ্ধতি –
- পচা, বাসি এবং আঢাকা খাবার গ্রহণ করলে,
- দূষিত এন্টামিবা হিস্টোলাইটিকা জলপানের ফলে,
- অস্বাস্থ্যকর পরিবেশে বসবাস করলে,
- হাত না ধুয়ে খাদ্য গ্রহণ করার ফলে এই রোগের জীবাণু এন্টামিবা হিস্টোলাইটিকা দেহে প্রবেশ করে ও রোগ সংক্রমণ ঘটে।
রোগ প্রতিরোধ ব্যবস্থা –
- হাত ধুয়ে খাবার খেতে হবে,
- খাবার ঢেকে রাখতে হবে যাতে মাছি বসতে না পারে,
- শাকসবজি ভালোভাবে ধুয়ে খেতে হবে,
- সঠিক চিকিৎসা করে এই রোগ প্রতিরোধ করা যায়।
ম্যালেরিয়া রোগের প্রকৃতি, উপসর্গ, সংক্রমণ পদ্ধতি ও প্রতিরোধ ব্যবস্থা সংক্ষেপে লেখো।
রোগের নাম – ম্যালেরিয়া।
রোগের প্রকৃতি – ম্যালেরিয়া প্লাসমোডিয়াম নামক একটি পরজীবী বা আদ্যপ্রাণীঘটিত রোগ। প্লাসমোডিয়ামের 4টি প্রজাতি দ্বারাই এই রোগ সংক্রামিত হয়। প্রজাতিগুলি হল – Plasmodium vivax, P. falciperum, P. malariae, P. ovale
রোগের লক্ষণ বা উপসর্গ –
- রোগীর কাঁপুনি দিয়ে জ্বর আসে।
- দেহের তাপমাত্রা বেড়ে যায় প্রায় 102° – 105° F।
- 3-4 ঘণ্টা পর প্রচণ্ড ঘাম দিয়ে জ্বর ছাড়ে এবং দেহের তাপমাত্রা কমে যায়।
- মাথায় অসহ্য যন্ত্রণা হয় ও বমিভাব আসে।
- প্লীহা বড়ো হয়ে যায়, রক্তাল্পতা দেখা দেয়।
রোগ সংক্রমণ পদ্ধতি –
- প্লাসমোডিয়াম পরজীবী এই রোগ ছড়ায় এবং স্ত্রী অ্যানোফিলিস মশকী এই পরজীবীর বাহকরূপে কাজ করে।
- ম্যালেরিয়া রোগাক্রান্ত রোগীর রক্ত শোষণ করার সময় এই জীবাণুর একটি বিশেষ দশা (গ্যামেটোসাইট) মশকীর দেহে প্রবেশ করে।
- এরপর মশকীর দেহে ওই দশা স্পোরোজয়েট দশায় রূপান্তরিত হয় ও মশকীর লালাগ্রন্থিতে বাস করে।
- ওই মশকীটি যখন কোনো সুস্থ ব্যক্তির দেহ থেকে রক্ত শোষণ করে তখন স্পোরোজয়েট দশা সুস্থ ব্যক্তির দেহে প্রবেশ করে এবং ব্যক্তিটি রোগাক্রান্ত হয়।
রোগ প্রতিরোধ ব্যবস্থা –
এই রোগ প্রতিরোধের উপায়গুলি হল –
- কোথাও জল জমতে দেওয়া চলবে না কারণ পরিষ্কার জলেই মশারা ডিম পাড়ে,
- মশারি ব্যবহার করতে হবে,
- রোগীর সঠিক চিকিৎসা করতে হবে।
ডিপথেরিয়া রোগের প্রকৃতি কেমন? এই রোগের উপসর্গ, সংক্রমণ পদ্ধতি ও প্রতিরোধ ব্যবস্থা উল্লেখ করো।
রোগের নাম – ডিপথেরিয়া।
রোগের প্রকৃতি – ডিপথেরিয়া হল করিনিব্যাকটেরিয়াম ডিপথেরি (Corynebacterium diphtheriae) নামক ব্যাকটেরিয়া ঘটিত ছোঁয়াচে রোগ।

রোগের উপসর্গ –
- নাসাপথ, শ্বাসনালীর ঊর্ধ্বভাগে মিউকাস স্তরে স্ফীতি ও প্রদাহ ঘটে।
- শ্বাসনালী মিউকাস দ্বারা বন্ধ হয়ে যায়, শ্বাসকষ্ট হয়,
- জ্বর হয়, গলায় ও ত্বকে ঘা দেখা দেয়। খাবার খেতে, ঢোক গিলতে কষ্ট হয়।
রোগ সংক্রমণ পদ্ধতি –
- করিনিব্যাকটেরিয়াম ডিপথেরি নামক ব্যাকটেরিয়া বাতাসে ছড়িয়ে পড়ে এই রোগ ঘটায়।
- বায়ুর মাধ্যমে সংক্রামিত হয়।
- আক্রান্ত রোগীর হাঁচি, কাশির সঙ্গে নির্গত মিউকাস কণাতে জীবাণু থাকে, যা প্রশ্বাস বায়ুর মাধ্যমে সংক্রামিত হয়।
রোগ প্রতিরোধ ব্যবস্থা – অ্যান্টিবায়োটিক ও DPT টিকাকরণের মাধ্যমে এই রোগ প্রতিরোধ করা সম্ভব।
নিউমোনিয়া রোগের প্রকৃতি, রোগলক্ষণ ও সংক্রমণ পদ্ধতি সংক্ষেপে লেখো।
রোগের নাম – নিউমোনিয়া।
রোগের প্রকৃতি – স্ট্রেপটোকক্কাস নিউমোনি (Streptococcus pneumoniae) নামক ব্যাকটেরিয়া ঘটিত ছোঁয়াচে রোগ।

রোগের লক্ষণ –
- আক্রান্ত ব্যক্তির জ্বর ও কাশি হয় এবং কাশির সঙ্গে কফ নির্গত হয়,
- রোগীর শ্বাসকষ্ট দেখা দেয়। দ্রুত ও অগভীর শ্বাসকার্য ঘটে।
- ফুসফুসের বায়ুধারণ ক্ষমতা কমে যায়, রক্তচাপ কমে যায়। বুকে তীব্র ব্যথা ও দুর্বলতা বোধ হয়।
- এছাড়াও ক্ষুধামান্দ্য, ক্লান্তি, বমিভাব, অস্থিসন্ধিতে ব্যথা অনুভূত হয়।
রোগসংক্রমণ পদ্ধতি –
- বায়ুর মাধ্যমে সংক্রামিত হয়,
- আক্রান্ত ব্যক্তির হাঁচি, কাশির মাধ্যমে নিউমোনিয়া রোগের জীবাণু স্ট্রেপটোকক্কাস নিউমোনি বাতাসে ছড়িয়ে পড়ে ও রোগ সংক্রমণ ঘটায়।
রোগ প্রতিরোধ ব্যবস্থা – অ্যান্টিবায়োটিকের মাধ্যমে এই রোগ প্রতিরোধ করা সম্ভব।
টিটেনাস রোগের প্রকৃতি, লক্ষণ, সংক্রমণ পদ্ধতি এবং প্রতিরোধ সম্পর্কে সংক্ষিপ্ত ধারণা দাও।
রোগের নাম – টিটেনাস।
রোগের প্রকৃতি – সংক্রমণযোগ্য (Communicable) রোগ। ক্লস্টিডিয়াম টিট্যানি (Clostridium tetani) নামক ব্যাকটেরিয়ার দ্বারা এই রোগ সংক্রমণ ঘটে।

রোগের উপসর্গ –
- পেশির যন্ত্রণাদায়ক সংকোচন ঘটে, বিশেষ করে গলা ও চোয়ালের পেশির। এই লক্ষণের জন্য একে ‘Lockjaw’ বা ‘টিট্যানি’ রোগ বলে।
- মোটর নিউরোনের অবক্ষয়ের ফলে পেশি দৃঢ় হয়ে যায় এবং প্যারালাইসিস বা পেশি অসাড়তার সৃষ্টি হয়।
- বুক, ঘাড়, পিঠ, চোয়ালে পেশিতে টান ধরে এবং খিঁচুনি দেখা যায়। চোয়াল আটকে যায়।
- হাত-পায়ে খিঁচুনি হয়, খাবার চিবোতে অসুবিধা হয়।
রোগসংক্রমণ পদ্ধতি – দেহের ক্ষতস্থান জীবাণুপূর্ণ মাটি বা অন্য পদার্থের সংস্পর্শে এলে ক্লস্টিডিয়াম টিট্যানি নামক ব্যাকটেরিয়া ওই কাটাস্থানে সংক্রমণ ঘটায় এবং এই রোগ ঘটে।
রোগ প্রতিরোধ ব্যবস্থা – দুর্ঘটনাজনিত ক্ষত বা কেটে গেলে 24 ঘণ্টার মধ্যে অ্যান্টিটিটেনাস ইনজেকশন বা DPT বা TT ভ্যাকসিন নেওয়া উচিত।
যক্ষ্মা রোগের প্রকৃতি, দায়ী জীবাণু, রোগলক্ষণ, সংক্রমণ পদ্ধতি এবং প্রতিরোধ সম্পর্কে সংক্ষিপ্ত ধারণা দাও।
রোগের নাম – যক্ষ্মা।
রোগের প্রকৃতি – বায়ুবাহিত, ব্যাকটেরিয়াঘটিত ছোঁয়াচে, সংক্রমণক্ষম রোগ। মাইকোব্যাকটেরিয়াম টিউবারকিউলোসিস (Mycobacterium tuberculosis) নামক ব্যাকটেরিয়া দ্বারা সংক্রমণ ঘটে।
রোগের উপসর্গ –
- প্রাথমিক লক্ষণ হিসেবে ঘনঘন কাশি হয়।
- সন্ধের দিকে জ্বর আসে এবং রাত্রিবেলা ঘাম হয়।
- বুকে ব্যথা এবং কাশির সময় থুতুর সঙ্গে রক্ত পড়ে।
- প্রচণ্ড দুর্বল বোধ, ওজন হ্রাস, খিদে কমে যায়।
রোগসংক্রমণ পদ্ধতি –
- রোগাক্রান্ত ব্যক্তির শরীর থেকে প্রত্যক্ষ বা পরোক্ষভাবে সুস্থদেহে সংক্রামিত হয়।
- এটি বায়ুবাহিত রোগ। রোগাক্রান্ত ব্যক্তির হাঁচি, কাশি, কফ বা থুতুর সঙ্গে জীবাণু বাতাসে ছড়িয়ে পড়ে।
- প্রশ্বাস বায়ুর মাধ্যমে জীবাণু দেহে প্রবেশ করে এবং রোগ সৃষ্টি করে।
- মাছির দ্বারাও অনেকসময় যক্ষ্মারোগের জীবাণু খাদ্য ও পানীয় -এর মাধ্যমে সুস্থ ব্যক্তির দেহে সংক্রামিত হয়।
রোগ প্রতিরোধ ব্যবস্থা –
- BCG (Bacillus Calmette and Guerin) টিকা দেওয়া।
- সঠিক স্বাস্থ্যবিধি মেনে চলা উচিত।
হেপাটাইটিস A ও B রোগের প্রকৃতি, উপসর্গ, সংক্রমণ পদ্ধতি ও প্রতিরোধ ব্যবস্থা ছকের সাহায্যে লেখো।
| রোগের নাম | রোগের প্রকৃতি | রোগের উপসর্গ | সংক্রমণ পদ্ধতি | প্রতিরোধ ব্যবস্থা |
| হেপাটাইটিস-A HAV | হেপাটাইটিস-A ভাইরাস বা HAV (RNA যুক্ত ভাইরাস) ঘটিত সংক্রামক রোগ। | 1. জ্বর, মাথাব্যথা, গাঁটে ব্যথা ও দুর্বলতা দেখা যায়। 2. ক্ষুধামান্দ্য ও বমিভাব হয়। 3. রোগীর শরীরে জ্বালাবোধ হয় এবং রোগী গাঢ় হলুদ রঙের মূত্র ত্যাগ করে। | 1. রোগাক্রান্ত ব্যক্তির মলের সঙ্গে HAV পরিবেশে ছড়িয়ে পড়ে। 2. ভাইরাস সংক্রামিত দূষিত জল, আঢাকা খাবার ও দুধের মাধ্যমে সুস্থ দেহে জীবাণু সংক্রামিত হয়। | 1. পরিষ্কার পরিচ্ছন্ন থাকতে হবে ও পুষ্টিকর খাবার খেতে হবে। 2. নিকাশি নালার জলের সঙ্গে খাবার জল যাতে না মেশে লক্ষ রাখতে হবে। |
| হেপাটাইটিস-B HBV | হেপাটাইটিস-B ভাইরাস বা HBV (DNA যুক্ত ভাইরাস) ঘটিত সংক্রামক রোগ। | 1. জ্বর, মাথা-ব্যথা, গাঁটে ব্যথা ও দুর্বলতা অনুভূত হয়। 2. বমিভাব ও ক্ষুধামান্দ্য দেখা দেয়। 3. রোগীর ডায়ারিয়া হয় ও রোগী গাঢ় হলুদ রঙের মূত্র ত্যাগ করে। 4. যকৃৎ স্ফীত হয় ফলে পেটের ওপরের দিকে ব্যথা অনুভূত হয়। | 1. সংক্রামিত ব্যক্তির লালা, বীর্য ও রক্তের মাধ্যমে সুস্থ দেহে জীবাণু সংক্রামিত হয়। 2. মায়ের শরীর থেকে গর্ভস্থ ভ্রূণের দেহে সংক্রামিত হয়। 3. রোগীর ব্যবহৃত সিরিঞ্জ, ব্লেড ও ছুঁচ থেকেও এই রোগ সংক্রমণ ঘটে। | 1. রোগীর রক্তের সঙ্গে সুস্থ ব্যক্তির রক্তের সংক্রমণ যেন না ঘটে লক্ষ রাখতে হবে। 2. প্রয়োজনে টিকা নিতে হবে। |
ধৌতকরণ কাকে বলে? রোগ নিরাময়ে ধৌতকরণের ভূমিকা আলোচনা করো। অথবা, মানবস্বাস্থ্যের নিরাপত্তায় ধৌতকরণের গুরুত্ব কী?
ধৌতকরণ (Wash) – যে বিশুদ্ধকরণ কর্মপদ্ধতির দ্বারা বিভিন্ন জীবাণুনাশক সাবান, ডিটারজেন্ট, লোশন, স্প্রে বা রুমাল ব্যবহার দ্বারা মানবদেহ বিশেষত হাত-পা, মুখ, নখ, চুল, দাঁত, ত্বক, চোখ, কান প্রভৃতি, বাড়িঘর, পোশাক-পরিচ্ছদ পরিষ্কার পরিচ্ছন্ন ও জীবাণুমুক্ত রাখা হয়, তাকে ধৌতকরণ বলে।
রোগ নিরাময়ে ধৌতকরণের ভূমিকা –
শারীরিক ধৌতকরণ –
মানবদেহকে রোগমুক্ত রাখতে হলে যেমন বিশুদ্ধ পানীয় জল, টাটকা স্বাস্থ্যকর খাদ্যের প্রয়োজন তেমনই প্রয়োজন দেহের সামগ্রিক পরিষ্কার পরিচ্ছন্নতার। এর জন্য নিম্নলিখিত ধৌতকরণ পদ্ধতিগুলি অবলম্বন করা উচিত –
- পরিষ্কার এবং সুস্থ ত্বক ব্যাকটেরিয়া, ছত্রাক, মাইট প্রভৃতি রোগ সৃষ্টিকারী জীবাণু বা প্যাথোজেন দেহে প্রবেশে বাধা দেয়। ব্যাকটেরিয়া, ছত্রাক ও মাইটঘটিত রোগসংক্রমণ থেকে রক্ষা পেতে হলে উপযুক্ত জীবাণুনাশক সাবান বা লোশন ব্যবহার দ্বারা ত্বককে নিয়মিত ধৌতকরণের প্রয়োজন।
- মাথা অপরিষ্কার থাকলে উকুন জন্মাতে পারে। নিয়মিত শ্যাম্পু, সাবান দিয়ে স্নান করলে মাথা ও দেহ পরিষ্কার থাকে এবং উকুন, মাইট (স্ক্যাবিজ রোগ সৃষ্টি করে) প্রভৃতির সংক্রমণ থেকে রেহাই পাওয়া যায়।
- বেশিরভাগ রোগ-সংক্রমণ ঘটে আমাদের হাত ও নখের মাধ্যমে। প্রধানত সর্দিকাশি, গ্যাস্ট্রোএনটেরাইটিস প্রভৃতি রোগের জীবাণুগুলি হাতের মাধ্যমে আমাদের দেহে সংক্রামিত হয়। উপযুক্ত জীবাণুনাশক সাবান বা লোশন দ্বারা ধৌতকরণের মাধ্যমে আমরা এই সমস্ত রোগের হাত থেকে রক্ষা পেতে পারি। প্রতিদিন দুবার দাঁত মাজার অভ্যাস দাঁত ও মাড়িকে সবল রাখে এবং ক্যাভিটি, মাডি থেকে রক্ত পড়া, মুখে দুর্গন্ধ হওয়া প্রতিরোধ করে।
- বাগান তৈরির সময় বা অন্য কোনো কাজে নখ অপরিষ্কার হয়, এর মাধ্যমে আমাদের দেহে অ্যাসকেরিয়েসিস রোগের সংক্রমণ ঘটতে পারে। ধৌতকরণের দ্বারা এই সম্ভাবনা থাকে না।

বাড়ি ধৌতকরণ –
পরিষ্কার-পরিচ্ছন্ন, আলোবাতাস যুক্ত বাড়ি নীরোগ, সুস্থ জীবনের সহায়ক। এজন্য বাড়ি ধৌতকরণের গুরুত্ব অপরিসীম। যেমন –
- প্রতিদিন বাড়িঘর ঝাঁট দিয়ে নোংরা আবর্জনা ফেলে দেওয়া দরকার। এরপর লাইজল, ডেটল প্রভৃতি জলে মিশিয়ে মেঝে ও অন্যান্য স্থান ভালোভাবে মুছে নেওয়া উচিত।
- বাড়ির আশপাশের স্থান, বিশেষ করে নালানর্দমার চারপাশ, টয়লেট, বাথরুম প্রভৃতি স্থান নিয়মিত ডিসইনফেকট্যান্ট দ্বারা ধুয়ে ফেলা দরকার।

পোশাক পরিচ্ছদ ধৌতকরণ – আমাদের জামাকাপড়, বিছানার চাদর, বালিশের ঢাকনা প্রভৃতি নিয়মিত ভালোভাবে পরিষ্কার করা দরকার। প্রতিদিন ধোয়া জামাকাপড়, অন্তর্বাস, রুমাল প্রভৃতি ব্যবহার করলে বিভিন্ন রোগের হাত থেকে রেহাই পাওয়া যায়। পোশাক-পরিচ্ছদ নিয়মিত ধৌতকরণের মাধ্যমে দাদ, একজিমা, স্ক্যাবিজ, চুলকানি প্রভৃতি রোগ প্রতিরোধ করা সম্ভব হয়। ডেটল, স্যাভলন জলে রোগীর পোশাক-পরিচ্ছদ ধোয়া উচিত। প্রতিদিন জামাকাপড় পরিষ্কার রাখার জন্য ডিটারজেন্ট ব্যবহার করা হয়।

মানবকল্যাণে জীবাণুদের ভূমিকা বর্ণনা করো।
মানবকল্যাণে জীবাণুদের ভূমিকা –
- খাদ্য উৎপাদনে – ফার্মেনটেশন পদ্ধতিতে বিভিন্ন ব্যাকটেরিয়াকে কাজে লাগিয়ে যেমন – ল্যাকটোব্যাসিলাস ল্যাকটিস (Lactobacillus lactis)-কে দুধ থেকেদই, মাখন, চিজ প্রভৃতি প্রস্তুতিতে, স্ট্রেপটোকক্কাস থার্মোফিলাস (Streptococcus thermophilus) ব্যাকটেরিয়াকে ছানা থেকে পনির প্রস্তুতিতে, লিউকোনস্টক (Leuconostoc) -কে দুধ থেকে চিজ প্রস্তুতিতে ব্যবহার করা হয়।
- ওষুধ উৎপাদনে – জীবাণুনাশক বিভিন্ন প্রকার অ্যান্টিবায়োটিক প্রস্তুতিতে জীবাণুকে কাজে লাগানো হচ্ছে, যেমন – স্ট্রেপটোমাইসিস (Streptomyces) থেকে স্ট্রেপটোমাইসিন, ব্যাসিলাস পলিমিক্সা (Bacillus polymyxa) থেকে পলিমিক্সিন-B, ব্যাসিলাস সাবটিলিস (Bacillus subtilis) থেকে ব্যাসিট্রাসিন উৎপন্ন করা হয়।
- অণুজীবসার – জমিতে রাসায়নিক সার প্রয়োগের কুফলতা, পরিবেশদূষণ কমানোর জন্য একাধিক অণুজীবকে জমিতে সার হিসেবে ব্যবহার করা হয়। বর্তমানে কৃষিজমিতে অ্যানাবিনা (Anabaena), নস্টক (Nostoc), অ্যাজোটোব্যাকটর (Azotobacter) প্রভৃতি অণুজীবীকে ব্যবহার করা হচ্ছে। এরা জমির উর্বরতা ধরে রাখতে সাহায্য করে। এছাড়াও বর্তমানে রাইজোবিয়াম, মাইকোরাইজাকেও ব্যবহার করা হচ্ছে।
- পেস্টের জৈবিক নিয়ন্ত্রণ – পতঙ্গ পেস্টের জৈবিক নিয়ন্ত্রণে ব্যাসিলাস থুরিনজিয়েনসিস (Bacillus thuringiensis) নামক ব্যাকটেরিয়াকে ব্যবহার করা হয়। পতঙ্গের জৈবিক নিয়ন্ত্রণে Nuclear Polyhedrosis virus (NPV) -কে ব্যবহার করা হয়।
- ভ্যাকসিন প্রস্তুতিতে – বিভিন্ন রোগের ভ্যাকসিন প্রস্তুতিতে অণুজীবকে ব্যবহার করা হচ্ছে। যেমন – হেপাটাইটিস ভাইরাস থেকে হেপাটাইটিস ভ্যাকসিন, র্যাবিস ভাইরাস থেকে র্যাবিস ভ্যাকসিন, ভিব্রিও কলেরি (Vibrio cholerae) ব্যাকটেরিয়া থেকে কলেরার টিকা, মৃত মাইকোব্যাকটেরিয়াম টিউবারকিউলোসিস (Micobacterium tuberculosis) ব্যাকটেরিয়া থেকে যক্ষ্মার BCG টিকা তৈরি করা হচ্ছে।।
- ভিটামিন প্রস্তুতিতে – বর্তমানে ক্লসট্রিডিয়াম (Clostridium) -কে ব্যবহার করে রাইবোফ্ল্যাভিন, গ্লুকানোব্যাকটর (Glucanobacter) -কে ব্যবহার করে Vitamic C প্রস্তুত করা হচ্ছে যা মানবকল্যাণে ব্যবহৃত হচ্ছে।
- মদশিল্পে – ফলের রস, খেজুরের রসকে কয়েকপ্রকার ব্যাকটেরিয়া, ছত্রাকের মাধ্যমে ফারমেনটেশন পদ্ধতিতে গেঁজিয়ে মদ প্রস্তুত করা হয়।
- বিকল্প খাদ্যরূপে SCP উৎপাদনে – বর্তমানে বিকল্প খাদ্য হিসেবে মানুষ ও অন্যান্য গবাদি ও পোলট্রি প্রাণীগুলিকে single cell protein প্রদান করা হয়। এই SCP উৎপাদনে স্পিরুলিনা (Spirulina sp.), ক্লোরেল্লা (Chlorella sp.) সহ আরো একাধিক অণুজীবকে ব্যবহার করা হচ্ছে।
জৈবিক নিয়ন্ত্রণ বলতে কী বোঝো? জৈবিক নিয়ন্ত্রণে ব্যাকটেরিয়া, ভাইরাস ও প্রোটোজোয়ার ভূমিকা ছকের মাধ্যমে আলোচনা করো।
জৈবিক নিয়ন্ত্রণ (Biological Control) – মানুষের প্রত্যক্ষ বা পরোক্ষভাবে ক্ষতিকারক পেস্টকে শত্রু প্রাণী বা খাদক প্রাণী দ্বারা নিয়ন্ত্রণ পদ্ধতিকে জৈবিক নিয়ন্ত্রণ বলে।
| জৈবিক নিয়ন্ত্রণে ব্যবহৃত জীবাণু | জৈবিক নিয়ন্ত্রণে ভূমিকা |
| ব্যাকটেরিয়া | 1. ব্যাসিলাস থুরিনজিয়েনসিস (Bacillus thuringiensis) নামক ব্যাকটেরিয়া লেপিডপটেরা শ্রেণিভুক্ত ফসল নষ্টকারী পতঙ্গের লার্ভাকে ধ্বংস করে, পতঙ্গের ‘মিল্কি ডিজিজ’ (Milky disease) রোগ সৃষ্টি করে। 2. ব্যাসিলাস পপিলি (Bacillus popilliae) নামক ব্যাকটেরিয়া জাপানি গুবরেপোকা দমন করে। 3. কোকোব্যাসিলাস অ্যাসিডোরাম (Coccobacillus acidorum) ব্যাকটেরিয়া পঙ্গপাল দমনে সাহায্য করে। |
| ভাইরাস | 1. পৃথিবীতে প্রায় 650টি প্রজাতির রোগপোকা দমনে ভাইরাসকে ব্যবহার করা হয়। 2. ব্যাকিউলোভাইরাস বা নিউক্লিয়ার পলিহেড্রোসিস ভাইরাস (NPV), হেলিকোভার্পা, আর্মিজেরা প্রভৃতি রোগপোকার জৈব নিয়ন্ত্রণে ব্যবহৃত হয়। 3. NPV (Nuclear Polyhedrosis Virus) ভাইরাসের সাহায্যে জিপসি মথ দমন করা হয়। 4. বায়োট্রোল নামক ভাইরাস কটন বল, টোব্যাকো বার্ড, কর্ন ওয়ার্ম প্রভৃতি কীটকে নিয়ন্ত্রণ করে। |
| প্রোটোজোয়া | 1. নোসেমা লোকাস্টি (Nosema locustae), লেপ্টোমোনাস (Leptomonas sp.) প্রভৃতি প্রোটোজোয়া বিভিন্ন রোগপোকার পরজীবীরূপে তাদের জৈব নিয়ন্ত্রণ করে। N. locustae পঙ্গপালকে আক্রমণ করে নিয়ন্ত্রণ করে। 2. পেরিজিয়া পাইরস্টি (Perezia pyraustae) নামক প্রোটোজোয়া দ্বারা কর্নবোরারকে দমন করা হয়। |
অণুজীবসার (Biofertilizer) কাকে বলে? অণুজীবসারের প্রকারভেদগুলি উল্লেখ করো।
অণুজীবসার (Biofertilizer) – যে-সমস্ত অণুজীব এককভাবে বা মিশ্রিতভাবে কৃষিজমিতে নাইট্রোজেন, ফসফেট প্রভৃতি পুষ্টি উপাদানের পরিমাণ বৃদ্ধি করে মাটির উর্বরতা বাড়িয়ে দেয় এবং উদ্ভিদের বৃদ্ধি ও উৎপাদনকে বাড়িয়ে তোলে, তাদের অণুজীবসার বা বায়োফার্টিলাইজার (Biofertilizer) বলা হয়।
অণুজীবসারের প্রকারভেদ –

অণুজীবসাররূপে ব্যাকটেরিয়ার ভূমিকা আলোচনা করো।
অণুজীবসাররূপে ব্যাকটিরিয়ার ভূমিকা –
- মিথোজীবী ব্যাকটেরিয়ার ভূমিকা –
- রাইজোবিয়াম লেগুমিনোসেরাম (Rhizobium leguminosarum), রাইজোবিয়াম মেলিলোটি (Rhizobium meliloti) প্রভৃতি মিথোজীবী ব্যাকটেরিয়া শিম্বিগোত্রীয় (ডালশস্য) উদ্ভিদের মূলে অর্বুদ সৃষ্টি করে বসবাস করে। এই ব্যাকটেরিয়াগুলি বায়ুমণ্ডলের মুক্ত নাইট্রোজেনকে নাইট্রেট লবণ (NO3) রূপে নিজদেহে আবদ্ধ করে এবং মাটিতে নাইট্রোজেনের পরিমাণ বৃদ্ধি করে মাটিকে উর্বর করে তোলে।
- ফ্ল্যানকিয়া (Frankia sp.) নামক ব্যাকটেরিয়া ক্যাসুরিনা, মাইরিকা প্রভৃতি অশিম্বিগোত্রীয় উদ্ভিদমূলে মিথোজীবীরূপে এবং জ্যান্থোমোনাস (Xanthomonas sp.) নামক ব্যাকটেরিয়া আর্ডিসিয়া গাছের পাতায় মিথোজীবীরূপে বাস করে এবং নাইট্রোজেন সংবন্ধনে ভূমিকা পালন করে।
- স্বাধীনজীবী ব্যাকটেরিয়ার ভূমিকা B-
- তুলো, ভুট্টা, জোয়ার, ধান প্রভৃতি কৃষিজমিতে অ্যাজোটোব্যাকটর (Azotobacter sp.) প্রয়োগ করে (বাণিজ্যিক নাম – অ্যাজোটোব্যাকটেরিন) অনেক বেশি উৎপাদন বাড়ানো সম্ভব হয়েছে।
- রোডোসিউডোমোনাস (Rhodopseudomonas sp.) রোডোস্পাইরিলাম (Rhodospirillum sp.) প্রভৃতি স্বাধীনজীবী ব্যাকটেরিয়া মাটিতে নাইট্রোজেন আবদ্ধ করে।
- ফসফেট সংবন্ধনকারী ব্যাকটেরিয়া – সিউডোমোনাস (Pseudomonas sp.), থিয়োব্যাসিলাস (Thiobacillus sp.), মাইক্রোকক্কাস (Micrococcus) প্রভৃতি ব্যাকটেরিয়া ফসফেটযুক্ত জৈব ও অজৈব যৌগ থেকে ফসফাটেজ উৎসেচকের সাহায্যে ফসফেটকে পৃথক করে মাটিতে উদ্ভিদের গ্রহণযোগ্য ফসফেটের পরিমাণ বৃদ্ধি করে।

মাইকোরাইজা কাকে বলে? মাইকোরাইজার শ্রেণিবিভাগ করো।
মাইকোরাইজা (Mycorrhiza) – মৃত্তিকায় বসবাসকারী নির্দিষ্ট কিছু ছত্রাকের অনুসূত্রের সঙ্গে সংবহনকলা যুক্ত উদ্ভিদমূলের মিথোজীবীয় সহাবস্থানকে মাইকোরইজা বলে।
মাইকোরাইজার শ্রেণিবিভাগ –

- বহিঃমাইকোরাইজা/এক্টোমাইকোরাইজা – এই ক্ষেত্রে ছত্রাক অনুসূত্রগুলি মূলের বাইরে থাকে এবং মূলকে আচ্ছাদিত করে ম্যান্টল গঠন করে। ম্যান্টল থেকে হাইফি মূলের কর্টেক্স -এর মধ্যে বিস্তৃত থাকে যা পরিবেশ থেকে পুষ্টি উপাদান শোষণ করে মূলে প্রবেশ করায়। উদাহরণ – বহিঃমাইকোরাইজা গঠনকারী ছত্রাক অ্যামানিটা (Amanita), বলিটাস (Boletus) প্রভৃতি পাইনাস, পিসিয়া, সিড্রাস প্রভৃতি উদ্ভিদের মূলে বাস করে।
- অন্তঃমাইকোরাইজা/এন্ডোমাইকোরাইজা – এই ক্ষেত্রে ছত্রাক অনুসূত্রগুলি মূলের বাইরে কোনো ম্যান্টল গঠন করে না, আন্তঃকোশীয় অঞ্চলে বর্ধিত হয়। কোনো কোনো হাইফা কোশের মধ্যে ঢুকে গহ্বর (vesicle) বা কুণ্ডলীকৃত আরবাসকিউল (Arbuscule) গঠন করে। এই সম্পর্ককে বলে VAM বা Vesicular Arabuscular Mycorrhizae। উদাহরণ – অর্কিড মূলে গ্লোমাস (Glomus), অ্যাসপারজিলাস (Aspergillus), প্রভৃতি ছত্রাকের অণুসূত্র মিলিতভাবে এন্ডোমাইকোরাইজা গঠন করে।
- বহিঃ-অন্তঃ মাইকোরাইজা/এক্টেন্ডোমাইকোরাইজা – উদাহরণ – পাইনাস, পিসিয়া, লোরিক্স প্রভৃতি উদ্ভিদমূলে ক্ল্যাভেরিয়া (Clavaria) ছত্রাক বাস করে মাইকোরাইজা গঠন করে।

আজকের এই আর্টিকেলে আমরা নবম শ্রেণীর জীবন বিজ্ঞানের চতুর্থ অধ্যায় ‘জীববিদ্যা ও মানবকল্যাণ’ -এর রচনাধর্মী প্রশ্ন ও উত্তর নিয়ে আলোচনা করেছি। এই প্রশ্নগুলো নবম শ্রেণীর পরীক্ষা এবং যারা ভবিষ্যতে বিভিন্ন প্রতিযোগিতামূলক পরীক্ষার প্রস্তুতি নেবেন, তাদের জন্য অত্যন্ত গুরুত্বপূর্ণ।
আশা করি, আর্টিকেলটি আপনাদের উপকারে আসবে। যদি কোনো প্রশ্ন বা জিজ্ঞাসা থাকে, তবে আমাদের টেলিগ্রামে যোগাযোগ করতে পারেন; আমরা উত্তর দেওয়ার যথাসাধ্য চেষ্টা করবো। এছাড়া, লেখাটি প্রয়োজনীয় মনে হলে আপনার বন্ধু বা সহপাঠীদের সাথে শেয়ার করতে ভুলবেন না। ধন্যবাদ।






মন্তব্য করুন